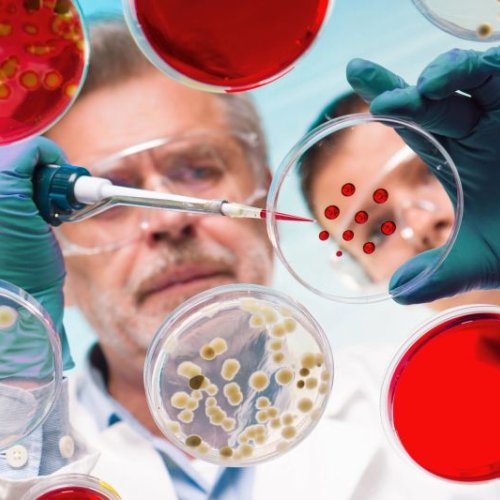
Genotoxicity, Carcinogenicity and Mutagenicity Studies

- View Mobile Number
iirtdelhi@gmail.com
Toxicity Studies
The Abnormal Toxicity Test (ATT) is a historical screening method used in the quality control of biological products, including vaccines, antitoxins, and other injectable formulations. The test aimed to identify unexpected toxic substances that might cause adverse reactions when administered. It involved injecting a sample into laboratory animals (usually mice or guinea pigs) to observe for signs of illness or death, indicating potential contamination.
Although once widely used, ATT has been largely phased out in many countries due to advancements in manufacturing controls, alternative validated methods, and ethical concerns regarding animal use.
Key Points:
-
Purpose: Detect unexpected toxic contaminants in injectable biological products.
-
Test subjects: Typically mice or guinea pigs.
-
Products tested: Vaccines, antitoxins, blood products, and other injectables.
-
Outcome: Observation for illness or death post-injection.
-
Current status: Largely replaced by modern, validated in vitro methods and improved GMP practices.
Acute Avian Toxicity Test
The Acute Avian Toxicity Test evaluates the toxic effects of chemicals or substances on birds over a short-term exposure. It is important for assessing environmental risks of pesticides, industrial chemicals, and contaminants to wild bird populations
Acute dermal toxicity studies are designed to assess the harmful effects of a single dose of a substance when applied to the skin. These studies are a critical part of toxicological evaluations and help determine the potential risks associated with short-term skin exposure. The data generated supports regulatory decisions, product labeling, and classification under systems like the Globally Harmonized System (GHS).
Key Objectives of Acute Dermal Toxicity Studies:
-
Identify immediate toxic effects after skin exposure
-
Determine LD₅₀ values (the dose lethal to 50% of test subjects)
-
Assess potential skin absorption and systemic toxicity
-
Support chemical safety assessments and risk evaluations
-
Aid in GHS hazard classification and labeling
These studies are typically conducted using animal models under strict ethical guidelines. The findings help ensure that substances—such as industrial chemicals, pesticides, or pharmaceuticals—are handled safely in both consumer and occupational settings.
Eye irritation studies are conducted to assess the potential of a substance to cause harmful or reversible effects to the eyes. These studies are crucial for ensuring the safety of chemicals, pharmaceuticals, cosmetics, and various consumer products that may come into direct or accidental contact with the eyes.
Such studies help identify:
-
Redness – indicating irritation of the conjunctiva (the eye’s outer membrane)
-
Swelling (edema) – showing tissue reaction or inflammation
-
Tearing or discharge – signs of discomfort or response to exposure
-
Corneal damage – which may affect vision and require medical attention
-
Reversibility of effects – determining if damage heals over time or is permanent
Eye irritation tests are used in both regulatory safety assessments and product development. Modern approaches aim to replace or reduce animal testing through validated in vitro alternatives such as reconstructed human corneal models, aligning with ethical and scientific advancements.
Acute inhalation toxicity studies are conducted to evaluate the harmful effects of a single or short-term exposure to a substance through the respiratory system. These studies help determine how toxic a chemical, gas, vapor, aerosol, or dust can be when inhaled, typically within a 24-hour period. The results are essential for risk assessment, safety labeling, and establishing occupational exposure limits.
Key Objectives of Acute Inhalation Toxicity Studies:-
Identify toxic effects of airborne substances after short-term exposure
-
Determine LC50 values (lethal concentration for 50% of test subjects)
-
Assess respiratory irritation or damage to lung tissue
-
Support regulatory classification for transportation and workplace safety
-
Guide emergency response and first aid measures
These studies are vital for industries that manufacture or handle volatile or airborne chemicals to ensure safe use, handling, and compliance with health regulations.
Acute oral toxicity studies are conducted to assess the harmful effects of a substance following a single dose or multiple doses within a 24-hour period administered orally. These studies are essential in toxicology and regulatory science as they provide initial information on a substance 's toxicity and potential health risks after short-term exposure.
The primary goal is to determine the LD₅₀ (lethal dose that kills 50% of test animals) or to estimate an approximate toxic dose. This data is crucial for classifying the toxicity level of chemicals and products and guiding labeling, handling, and safety precautions.
These studies help:
-
Identify toxic dose ranges
-
Classify chemicals by their acute toxicity level
-
Support hazard labeling and risk communication
-
Guide dosage selection for further long-term studies
-
Ensure safety during development of pharmaceuticals, chemicals, and consumer products
These studies typically use rodents and follow internationally recognized guidelines such as OECD Test Guideline 420, 423, or 425.
Systemic toxicity studies are conducted to evaluate the adverse effects of a substance on the entire body or specific organ systems following its absorption into the bloodstream. These studies help determine how a substance affects various physiological functions and organ health over time. They are a critical component of safety assessments for a wide range of products and substances.
These studies are important for evaluating the safety of:
-
Pharmaceuticals – to ensure drugs do not cause harmful effects at therapeutic doses
-
Chemicals – including those used in agriculture, industry, or cleaning products
-
Food additives – to verify safety for human consumption over time
-
Cosmetics – especially products absorbed through the skin
-
Industrial compounds – to assess occupational and environmental exposure risks
Systemic toxicity studies provide essential data for regulatory agencies to set exposure limits, labeling requirements, and usage guidelines to protect human and environmental health.
Acute irritation toxicity studies are conducted to assess whether a substance causes reversible damage to the skin, eyes, or respiratory tract after a single or short-term exposure. These studies are crucial in evaluating the safety of chemicals, pharmaceuticals, cosmetics, and various consumer products.
They help determine the irritation potential, which guides product labeling, handling precautions, and regulatory classification.
Key Aspects Assessed in Acute Irritation Studies:-
Skin irritation – redness, swelling, or damage to the skin surface
-
Eye irritation – tearing, redness, corneal damage, or visual impairment
-
Respiratory irritation – coughing, wheezing, or discomfort in the nose and throat
These studies are typically performed using in vitro or in vivo models, depending on regulatory requirements. Results play a vital role in ensuring user safety and complying with global safety regulations before a product is approved for market use.
The Acute Toxicity Test in Earthworms evaluates the toxic effects of chemicals or substances on earthworms, which are key soil organisms important for soil health and ecosystem functioning.
Ecological quality of compost and digestate, used as fertilizers for agricultural use, was assessed through an acute ecotoxicological bioassay testing the earthworm Eisenia fetida (Annelida). The test evaluates the earthworm’s attitude to dig within 15 min into a soil medium constituted by a mixture of a standardized soil and different concentrations of compost/digestate. According to different classes of behavior responses, the sample is classified as good or bad quality (ON/OFF). The validity of this test was confirmed comparing the observations with the results from a standard chronic test developed by OECD (Organisation for Economic Co-operation and Development). Considering samples from different plants and at different stages of degradations, the replicates, the number of tested concentrations and the measured endpoints (ability to dig, mortality, growth, reproduction), a total of 996 observations were analyzed. The chronic test on earthworms uses the same media as in the acute one and measures the endpoints of mortality and growth within 28 days and reproduction within further 28 days. Thus, the test proposed here can be considered a not expensive and quick laboratory test and its implementation in quality assurance (QA) and quality of product (QC) schemes would enhance the protection of soil fauna. This last purpose is very important considering that, concerning the biological indicators of the quality of compost and digestate, the most important studies focused on the use of plants and microorganisms and scarce attention has been paid to soil invertebrates.
The Acute Toxicity Test in Silkworm evaluates the immediate toxic effects of chemicals, drugs, or substances on silkworms (Bombyx mori). This test is gaining attention as a cost-effective and ethical alternative to mammalian acute toxicity studies.
Acute Toxicity fish
Acute toxicity testing in fish evaluates the harmful effects of a substance (e.g., chemical leachables, environmental contaminants) on aquatic organisms over a short exposure period. This test helps assess environmental safety and ecological risks.
Acute toxicity study is defined as an assessment that provides information on the adverse health effects of a substance following a large dose administration, evaluating potential lethal doses and identifying target organs for toxicity through biochemical, physiological, and morphological changes.
Acute irritation toxicity studies evaluate whether a substance causes reversible damage to the skin, eyes, or respiratory tract after a single or short-term exposure. These studies are essential for determining the irritation potential of chemicals, drugs, cosmetics, and other consumer products.
Testing of Acute Toxicity '6 Pack' Studies.
- Acute Oral
- Acute Inhalation
- Acute Dermal
- Acute Irritation
- Eye Irritation
Allergic sensitization studies are designed to evaluate whether a substance can trigger allergic reactions after repeated exposure, particularly through the skin (dermal route) or the respiratory system. These studies are essential for identifying the hypersensitivity potential of various substances and ensuring the safety of products before they reach consumers.
They are commonly conducted for:
-
Chemicals – used in industrial and household products
-
Pharmaceuticals – especially topical or inhaled drugs
-
Cosmetics and personal care products – such as lotions, creams, and fragrances
-
Consumer goods – including textiles, cleaning agents, and adhesives
These studies help detect immune system responses, such as skin inflammation, rashes, or respiratory issues like asthma, that can arise from allergen exposure. The results support regulatory decisions, product labeling, and risk assessments to prevent allergic reactions in sensitive individuals and protect public health.
This Test Guideline describes procedures designed to estimate the acute oral toxicity of substances to birds, and it provides three testing options: (1) limit dose test, (2) LD50-slope test, and (3) LD50-only test. The LD50-slope and LD50-only options are sequential testing procedures. The test method selected will depend on whether or not a definitive median dose (LD50) and slope of the dose-response curve are both needed. The limit dose test is the preferred test when toxicity is expected to be low and lethality is unlikely at the limit dose. The limit dose should be adequate for assessment purposes, and it is usually 2000 mg/kg-bwt. Five or ten birds are tested at the limit dose in addition to a control group.
The LD50-slope test is the preferred test when regulatory or other requirements determine that the slope of the dose-response curve and/or the confidence interval is required in addition to an estimate of the LD50. This is a 3- or 4-stage test with 24 or 34 birds in addition to a control group. The LD50-only test is the preferred test when regulatory or other requirements determine that only the median lethal dose is required but neither the slope of the dose response curve or the confidence interval for the LD50 is required. This may be the appropriate test to estimate a percentile of a species sensitivity distribution of LD50s and to provide information for product labelling purposes.
Chronic toxicity studies are long-term investigations conducted to evaluate the health effects of a substance after prolonged or lifetime exposure. Typically lasting from 6 months to 2 years, depending on the test species, these studies are essential for understanding the potential risks associated with continuous exposure to chemicals, pharmaceuticals, or environmental agents.
They help identify:
-
Cumulative toxicity – effects that build up in the body over time.
-
Target organs – specific organs that may be most affected by the substance.
- Carcinogenicity potential – the likelihood of the substance causing cancer.
- Safe exposure limits – thresholds below which the substance is considered safe for humans.
Chronic toxicity studies play a vital role in regulatory decision-making, supporting the development of safety guidelines and risk assessments to protect public health. They are especially important for substances used in food, medicine, and occupational settings.
Cytotoxicity studies are laboratory tests conducted to assess the harmful effects of a substance on cultured cells. These studies help determine whether a chemical, drug, or other material can damage cells, inhibit their growth, or cause cell death. Cytotoxicity testing is a key step in the early stages of product development, particularly for pharmaceuticals, cosmetics, medical devices, and environmental chemicals.
These studies are essential for:
-
Screening new compounds – to identify toxic effects before animal or human testing.
-
Evaluating cell viability – measuring the ability of cells to survive after exposure.
-
Detecting cell damage – including membrane disruption or organelle injury.
-
Assessing dose-response relationships – to determine the concentration at which a substance becomes harmful.
-
Ensuring product safety – especially in cosmetics, where human testing may be limited.
Cytotoxicity assays, such as MTT, LDH release, or Trypan Blue exclusion, provide quick, cost-effective, and ethical methods to predict potential toxicity.
These studies are essential components of toxicological risk assessment. They are designed to evaluate the potential of substances (such as chemicals, drugs, or environmental agents) to cause genetic damage, cancer, or heritable mutations.
Genetic toxicology (genetox) studies are conducted to assess the mutagenic potential of various products prior to widespread use in humans. Since DNA-reactive substances may initiate the carcinogenic process, screening strategies with built-in mode of action information are becoming more useful for biologically assessing potential human risk. The operable mechanisms (i.e., biological key events) can then be evaluated in the context of an adverse outcome pathway to identify a probable molecular initiating event responsible for the positive test results. While genetic toxicology testing is required for all classes of chemicals and drugs, the testing strategy should be tailored to the applicable regulatory requirements and responses observed in vitro. While most studies are performed in vitro, we also incorporate in vivo genetic toxicology studies, when necessary.
This Test Guideline is a laboratory test method, designed to assess the oral acute toxicity of pesticides and other chemicals, to adult worker honeybees. Adult worker honeybees are exposed to five doses in a geometric series of the test substance dispersed in sucrose solution. A minimum of three replicate test groups, each of ten bees, should be dosed with each test concentration. A toxic standard (usually dimethoate) should be included in the test series. The bees are then fed the same diet, free of the test substance.
The limit test corresponds to one dose level of 100 ìg active ingredient/bee. Mortality is recorded daily during at least 48 hours and compared with control values. If the mortality rate is increasing between 24 and 48h whilst control mortality remains at an accepted level it is appropriate to extend the duration of the test to a maximum of 96h. The study report should include the amount of diet consumed per group and the observation of all abnormal behavioural. The results are analysed in order to calculate the LD50 at 24h and 48h and, in case the study is prolonged, at 72h and 96h.
This Test Guideline is a laboratory test method, designed to assess the acute contact toxicity of pesticides and other chemicals to adult worker honeybees. Anaesthetized adult worker honeybees are exposed to five doses in a geometric series of the test substance dissolved in appropriate carrier (in total a volume of 1 ml), by direct application to the thorax (droplets). A minimum of three replicate test groups, each of ten bees, should be dosed with each test concentration. A toxic standard (usually dimethoate) should be included in the test series.
The limit test corresponds to one dose level of 100 ìg active ingredient/bee. The test duration is 48h. Mortality is recorded daily during at least 48 hours and compared with control values. If the mortality rate is increasing between 24 and 48h whilst control mortality remains at an accepted level, it is appropriate to extend the duration of the test to a maximum of 96h. The results are analysed in order to calculate the LD50 at 24h and 48h and, in case the study is prolonged, at 72h and 96h.
In vitro toxicity studies are laboratory-based assessments performed outside of living organisms, using systems such as cultured cells, tissue slices, or organotypic models. These studies aim to determine the toxic effects of substances at the cellular and molecular levels, offering valuable insights into their mechanisms of action. They are widely used in the early stages of safety evaluation and serve as a foundation for identifying potential hazards before advancing to in vivo testing.
Key features of in vitro toxicity studies include:
-
Use of non-animal models: Helps reduce reliance on animal testing by providing ethical and efficient alternatives.
-
Cellular and molecular focus: Assesses how substances affect cell viability, gene expression, and biochemical pathways.
Early safety screening: Identifies toxic compounds early in product development, saving time and resources. - Mechanistic insights: Reveals the underlying biological mechanisms of toxicity.\\n
-
Regulatory and research relevance: Supports regulatory decision-making and enhances understanding in toxicological research.
The Oral and Contact Toxicity Tests evaluate the effects of chemicals, especially pesticides, on honeybees (Apis mellifera), crucial pollinators in ecosystems. These tests assess the acute toxic effects through oral ingestion and direct contact exposure.
Honey bees (A. mellifera) can be exposed to pesticide residues by indirect contact on plant surfaces, via oral intake with contaminated food or water, or by direct contact during the course of application according to normal farming practice. If the proposed use pattern of pesticides indicates a possible exposure of honey bees, acute contact and oral toxicity studies shall be necessary for the registration of the pesticide in question.
Pharmacological study services involve a series of experimental investigations designed to evaluate the effects, mechanisms of action, efficacy, and safety of drugs, chemical compounds, or pharmaceutical formulations. These studies play a critical role in the drug development process by generating essential data needed for advancing candidates through preclinical and clinical stages, and ultimately gaining regulatory approval.
Key Objectives of Pharmacological Studies:-
Mechanism of action – Understanding how a drug interacts with biological systems.
-
Therapeutic efficacy – Assessing the drug’s ability to produce the desired effect.
-
Dose-response relationship – Determining the optimal therapeutic dose.
-
Safety and toxicity – Identifying potential adverse effects at various dosages.
-
Target identification and validation – Confirming biological targets for drug action.
These services are essential in both academic research and pharmaceutical industry settings, ensuring that new treatments are scientifically validated, safe, and effective for human use.
Leading Service provider for Abnormal Toxicity Studies, Acute Toxicity Studies, Allergic Toxicity Studies, Carcinogenicity Toxicity Studies, Chronic Toxicity Studies, Ecotoxicology Studies, Invitro Toxicity Studies, Irritation Toxicity Studies, Medical devices testing, Pharmacological Toxicity Studies, Reproductive Toxicity Studies, Sub Acute Toxicity Studies and Supplementary Toxicity Studies.